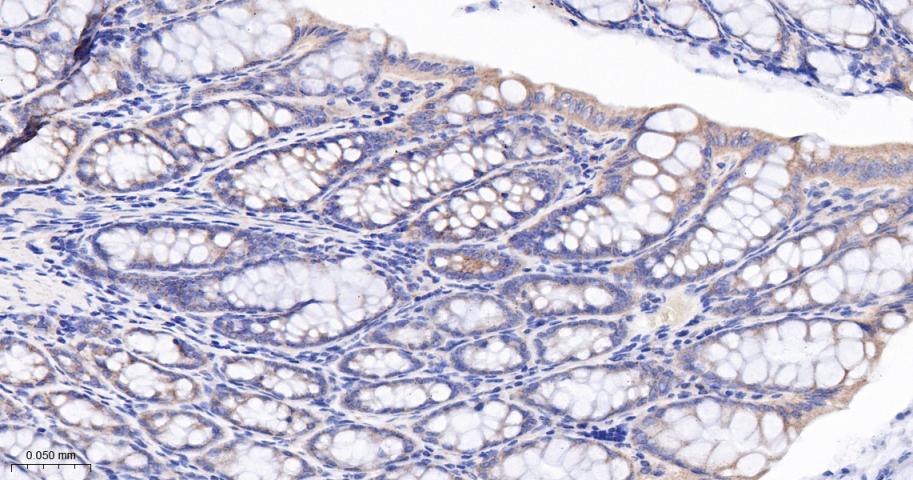
腺瘤样息肉重组兔单抗

腺瘤样息肉重组兔单抗
Rrmab?兔单抗

货号:bsm-61249R
产品详情
相关标记
相关产品
相关文献
常见问题
概述
产品编号
bsm-61249R
产品类型
重组兔单抗
英文名称
APC Recombinant Rabbit mAb
中文名称
腺瘤样息肉重组兔单抗
英文别名
BTPS2; DESMD; DP2; DP2.5; DP3; GS; PPP1R46; CC1; Min; mAPC; RATAPC; APC_HUMAN; APC; Protein APC; Deleted in polyposis 2.5; APC_MOUSE; APC_RAT;
抗体来源
Rabbit
免疫原
A synthesized peptide derived from human APC: 50-100/2843
亚型
IgG
性状
Liquid
纯化方法
affinity purified by Protein A
克隆类型
Recombinant
克隆号
2G8
理论分子量
312 kDa
检测分子量
160 kDa
储存液
10mM phosphate buffered saline(pH 7.4) with 150mM sodium chloride, 0.05% BSA, 0.02% Proclin300 and 50% glycerol.
研究领域
Cancer > Cell cycle > Cell division
Cancer > Oncoproteins/suppressors > Tumor suppressors > PTC & Wnt pathway
Cardiovascular > Heart > Cardiogenesis > Transcription factors/regulators
Cell Biology > Cell Cycle > Cell Division > Spindle
Epigenetics and Nuclear Signaling > Transcription > Cancer susceptibility > Tumor Suppressors
Neuroscience > Cell Type Marker > Glia marker > Oligodendrocyte marker
SWISS
Gene ID
保存条件
Store at 4℃ for short term. Store at -20℃ for long term. Avoid repeated freeze/thaw cycles.
注意事项
This product as supplied is intended for research use only, not for use in human, therapeutic or diagnostic applications.
数据库链接
背景资料
Promotes rapid degradation of CTNNB1 and participates in Wnt signaling as a negative regulator. APC activity is correlated with its phosphorylation state. Activates the GEF activity of SPATA13 and ARHGEF4. Plays a role in hepatocyte growth factor (HGF)-induced cell migration. Required for MMP9 up-regulation via the JNK signaling pathway in colorectal tumor cells. Associates with both microtubules and actin filaments, components of the cytoskeleton.

产品应用
| 应用 | 已检合格种属 | 预测种属 | 推荐稀释比例 |
|---|---|---|---|
| WB | Human, Mouse, Rat | 1:500-2000 | |
| IHC-P | Human, Mouse, Rat | 1:50-200 | |
| IHC-F | Human, Mouse, Rat | 1:50-200 | |
| IF | Human, Mouse, Rat | 1:50-200 | |
| IP | Human, Mouse, Rat | 1:20-50 |
交叉反应
交叉反应: Human, Mouse, Rat
相关产品
暂无相关产品
靶标
基因名
APC
蛋白名
Adenomatous polyposis coli protein
亚基
Forms homooligomers and heterooligomers with APC2. Interacts with DIAPH1 and DIAPH2. Interacts withPDZ domains of DLG1 and DLG3. Associates with catenins. Binds axin. Interacts with ARHGEF4 (via N-terminus). Interacts with MAPRE1 (viaC-terminus); probably required for APC targeting to the growingmicrotubule plus ends. Interacts with MAPRE2 and MAPRE3 (viaC-terminus). Found in a complex consisting of ARHGEF4, APC andCTNNB1. Interacts with SCRIB; may mediate APC targeting to adherensjunctions of epithelial cells. Interacts with SPATA13 (viaN-terminus and SH3 domain). Interacts with ASAP1 (via SH3 domain). Found in a complex composed of MACF1, APC, AXIN1, CTNNB1 and GSK3B. Interacts at the cell membrane with FAM123A and FAM123B (via ARM repeats).
亚细胞定位
Cell junction, adherens junction. Cytoplasm, cytoskeleton. Cell projection, lamellipodium. Cell projection, ruffle membrane. Cytoplasm. Cell membrane. Note=Associated with the microtubule network at the growing distal tip of microtubules. Accumulates in the lamellipodium and ruffle membrane in response to hepatocyte growth factor (HGF) treatment. The MEMO1-RHOA-DIAPH1 signaling pathway controls localization of the phosophorylated form to the cell membrane.
组织特异性
Expressed in a variety of tissues.
翻译后修饰
Phosphorylated by GSK3B.
Ubiquitinated, leading to its degradation by the proteasome. Ubiquitination is facilitated by Axin. Deubiquitinated by ZRANB1/TRABID.
Ubiquitinated, leading to its degradation by the proteasome. Ubiquitination is facilitated by Axin. Deubiquitinated by ZRANB1/TRABID.
疾病
Familial adenomatous polyposis (FAP) [MIM:175100]: A cancer predisposition syndrome characterized by adenomatous polyps of the colon and rectum, but also of upper gastrointestinal tract (ampullary, duodenal and gastric adenomas). This is a viciously premalignant disease with one or more polyps progressing through dysplasia to malignancy in untreated gene carriers with a median age at diagnosis of 40 years. Note=The disease is caused by mutations affecting the gene represented in this entry.
Hereditary desmoid disease (HDD) [MIM:135290]: Autosomal dominant trait with 100% penetrance and possible variable expression among affected relatives. HDD patients show multifocal fibromatosis of the paraspinal muscles, breast, occiput, arms, lower ribs, abdominal wall, and mesentery. Desmoid tumors appears also as a complication of familial adenomatous polyposis. Note=The disease is caused by mutations affecting the gene represented in this entry.
Medulloblastoma (MDB) [MIM:155255]: Malignant, invasive embryonal tumor of the cerebellum with a preferential manifestation in children. Note=The gene represented in this entry may be involved in disease pathogenesis.
Mismatch repair cancer syndrome (MMRCS) [MIM:276300]: Autosomal dominant disorder characterized by malignant tumors of the brain associated with multiple colorectal adenomas. Skin features include sebaceous cysts, hyperpigmented and cafe au lait spots. Note=The disease is caused by mutations affecting the gene represented in this entry.
Gastric cancer (GASC) [MIM:613659]: A malignant disease which starts in the stomach, can spread to the esophagus or the small intestine, and can extend through the stomach wall to nearby lymph nodes and organs. It also can metastasize to other parts of the body. The term gastric cancer or gastric carcinoma refers to adenocarcinoma of the stomach that accounts for most of all gastric malignant tumors. Two main histologic types are recognized, diffuse type and intestinal type carcinomas. Diffuse tumors are poorly differentiated infiltrating lesions, resulting in thickening of the stomach. In contrast, intestinal tumors are usually exophytic, often ulcerating, and associated with intestinal metaplasia of the stomach, most often observed in sporadic disease. Note=The gene represented in this entry may be involved in disease pathogenesis.
Hepatocellular carcinoma (HCC) [MIM:114550]: A primary malignant neoplasm of epithelial liver cells. The major risk factors for HCC are chronic hepatitis B virus (HBV) infection, chronic hepatitis C virus (HCV) infection, prolonged dietary aflatoxin exposure, alcoholic cirrhosis, and cirrhosis due to other causes. Note=The gene represented in this entry may be involved in disease pathogenesis.
Hereditary desmoid disease (HDD) [MIM:135290]: Autosomal dominant trait with 100% penetrance and possible variable expression among affected relatives. HDD patients show multifocal fibromatosis of the paraspinal muscles, breast, occiput, arms, lower ribs, abdominal wall, and mesentery. Desmoid tumors appears also as a complication of familial adenomatous polyposis. Note=The disease is caused by mutations affecting the gene represented in this entry.
Medulloblastoma (MDB) [MIM:155255]: Malignant, invasive embryonal tumor of the cerebellum with a preferential manifestation in children. Note=The gene represented in this entry may be involved in disease pathogenesis.
Mismatch repair cancer syndrome (MMRCS) [MIM:276300]: Autosomal dominant disorder characterized by malignant tumors of the brain associated with multiple colorectal adenomas. Skin features include sebaceous cysts, hyperpigmented and cafe au lait spots. Note=The disease is caused by mutations affecting the gene represented in this entry.
Gastric cancer (GASC) [MIM:613659]: A malignant disease which starts in the stomach, can spread to the esophagus or the small intestine, and can extend through the stomach wall to nearby lymph nodes and organs. It also can metastasize to other parts of the body. The term gastric cancer or gastric carcinoma refers to adenocarcinoma of the stomach that accounts for most of all gastric malignant tumors. Two main histologic types are recognized, diffuse type and intestinal type carcinomas. Diffuse tumors are poorly differentiated infiltrating lesions, resulting in thickening of the stomach. In contrast, intestinal tumors are usually exophytic, often ulcerating, and associated with intestinal metaplasia of the stomach, most often observed in sporadic disease. Note=The gene represented in this entry may be involved in disease pathogenesis.
Hepatocellular carcinoma (HCC) [MIM:114550]: A primary malignant neoplasm of epithelial liver cells. The major risk factors for HCC are chronic hepatitis B virus (HBV) infection, chronic hepatitis C virus (HCV) infection, prolonged dietary aflatoxin exposure, alcoholic cirrhosis, and cirrhosis due to other causes. Note=The gene represented in this entry may be involved in disease pathogenesis.
相似性
Belongs to the adenomatous polyposis coli (APC) family.
Contains 7 ARM repeats.
Contains 7 ARM repeats.
功能
Tumor suppressor. Promotes rapid degradation of CTNNB1 and participates in Wnt signaling as a negative regulator. APC activity is correlated with its phosphorylation state. Activates the GEF activity of SPATA13 and ARHGEF4. Plays a role in hepatocyte growth factor (HGF)-induced cell migration. Required for MMP9 up-regulation via the JNK signaling pathway in colorectal tumor cells. Acts as a mediator of ERBB2-dependent stabilization of microtubules at the cell cortex. It is required for the localization of MACF1 to the cell membrane and this localization of MACF1 is critical for its function in microtubule stabilization.
标记抗体
暂无标记数据
同靶标产品
暂无同靶标产品
相关文献
提示: 发表研究结果有使用 bsm-61249R 时请让我们知道,以便我们可以引用参考文章。作为回馈,资料提供者将获得我们送上的小礼品。
暂无相关文献
常见问题
暂无常见问题